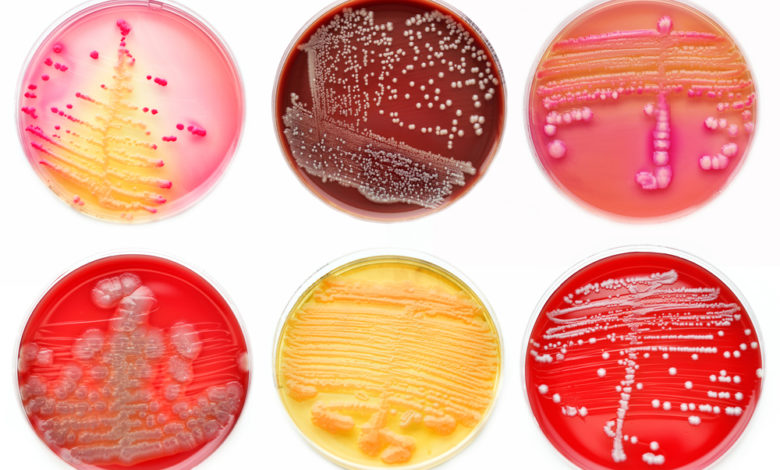
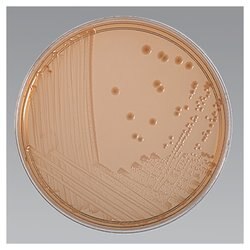
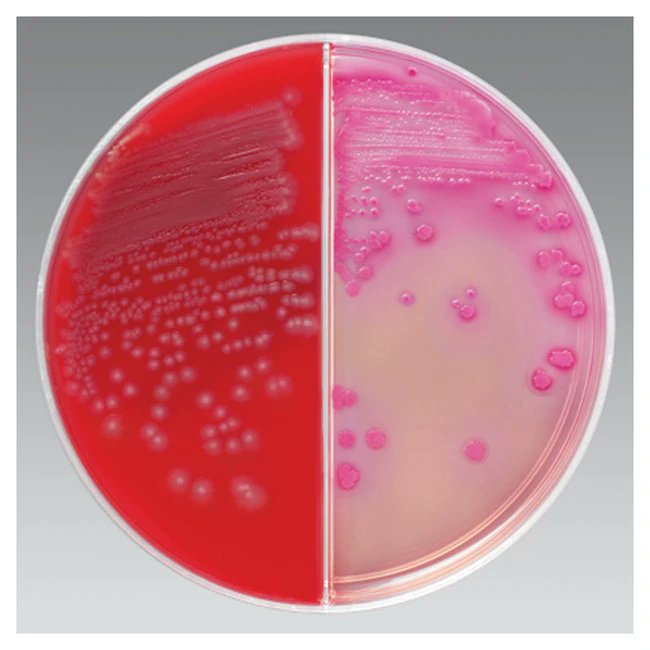

#تغريدة_في_تخصصك
عارفين هذي ايش؟
هذي أوساط غذائية تستخدم في قسم المايكروبيولوجي( الأحياء الدقيقة ) لتنمية البكتيريا ثم تحديد نوع المضاد الحيوي و العلاج المناسب لها
❤❤
عارفين هذي ايش؟
هذي أوساط غذائية تستخدم في قسم المايكروبيولوجي( الأحياء الدقيقة ) لتنمية البكتيريا ثم تحديد نوع المضاد الحيوي و العلاج المناسب لها
❤❤
#تغريده_في_تخصصك
الاوساط الغذائية لزراعة و تنمية البكتيريا عديدة و لكل وسط خصائصه و بعض أنواع البكتيريا لابد أن يتم زراعتها في أوساط معينة للكشف عنها
هذي الصور اللي شايفينها ترا من جد نشوفها في المختبر 😂❤
الاوساط الغذائية لزراعة و تنمية البكتيريا عديدة و لكل وسط خصائصه و بعض أنواع البكتيريا لابد أن يتم زراعتها في أوساط معينة للكشف عنها
هذي الصور اللي شايفينها ترا من جد نشوفها في المختبر 😂❤
#تغريدة_في_تخصصك
قسم المايكروبيولوجي( الأحياء الدقيقة ) من أصعب الأقسام اللي الموظف يشتغل
تحديد انواع البكتيريا ليس بالسهولة ابدا ابدا
يعني اللي يمسك هذا القسم من الصعب يطلع منه بصراحة .. شغله كثير و دقيق و عدوى و شغلته شغلة
اللي يشتغل مايكرو تقريبا شكله يكون 👇😂
قسم المايكروبيولوجي( الأحياء الدقيقة ) من أصعب الأقسام اللي الموظف يشتغل
تحديد انواع البكتيريا ليس بالسهولة ابدا ابدا
يعني اللي يمسك هذا القسم من الصعب يطلع منه بصراحة .. شغله كثير و دقيق و عدوى و شغلته شغلة
اللي يشتغل مايكرو تقريبا شكله يكون 👇😂
#تغريدة_في_تخصصك
اشكال البكتيريا بعد ما تم زراعتها .. طبعا هذي أمثلة بسيطة / بعض من أشياء كثيرة ..
ثم يتم الكشف عن أنواعها و معرفة ال zone غير خطوات التخفيف
❤❤
اشكال البكتيريا بعد ما تم زراعتها .. طبعا هذي أمثلة بسيطة / بعض من أشياء كثيرة ..
ثم يتم الكشف عن أنواعها و معرفة ال zone غير خطوات التخفيف
❤❤
#تغريده_في_تخصصك
اسماء البكتيريا ..
طبعا أيام الدراسة كنا ما ننام الليل نخاف ننساها من صعوبتها ..
اعطيكم أمثلة:
شاغيلا
نايسيريا
ستافيلو كوكس
كليبسيلا
اي كولاي
وكل بكتيريا مسببة لمرض معين 😉
و غيرهم و غيرهم ..
طبعا انا كتبتهم بالعربي و ياويلنا نغلط بالانجليزي 😂
اسماء البكتيريا ..
طبعا أيام الدراسة كنا ما ننام الليل نخاف ننساها من صعوبتها ..
اعطيكم أمثلة:
شاغيلا
نايسيريا
ستافيلو كوكس
كليبسيلا
اي كولاي
وكل بكتيريا مسببة لمرض معين 😉
و غيرهم و غيرهم ..
طبعا انا كتبتهم بالعربي و ياويلنا نغلط بالانجليزي 😂
جاري تحميل الاقتراحات...